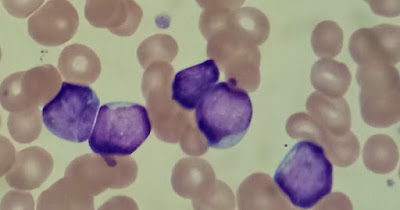

Con este sistema, los investigadores demostraron que podían introducir genes de hasta 36.000 pares de bases de ADN en varios tipos de células humanas, así como en células hepáticas de ratones. La nueva técnica, conocida como PASTE, podría ser prometedora para tratar enfermedades causadas por genes defectuosos con gran número de mutaciones, como la fibrosis quística.
La nueva herramienta combina la orientación precisa de CRISPR-Cas9, un conjunto de moléculas derivadas originalmente de los sistemas de defensa bacterianos, con enzimas llamadas integrasas, que con los virus utilizan para insertar su propio material genético en el genoma bacteriano.
El sistema de edición de genes CRISPR-Cas9 consiste en una enzima de corte de ADN llamada Cas9 y una cadena corta de ARN que guía a la enzima a un área específica del genoma, dirigiendo a Cas9 donde hacer su corte. Cuando Cas9 y el ARN guía dirigido a un gen enfermo se introducen en las células, se realiza un corte específico en el genoma y los procesos de reparación del ADN de las células pegan el corte, eliminando a menudo una pequeña porción del genoma.
Si también se suministra una plantilla de ADN, las células pueden incorporar una copia corregida en sus genomas durante el proceso de reparación. Sin embargo, este proceso requiere que las células realicen roturas de doble cadena en su ADN, lo que puede causar deleciones o reordenamientos cromosómicos perjudiciales para las células. Otra limitación es que sólo funciona en las células que se dividen, ya que las que no se dividen no tienen procesos de reparación del ADN activos.
El equipo del MIT quería desarrollar una herramienta que pudiera eliminar un gen defectuoso y sustituirlo por uno nuevo sin introducir ninguna rotura de doble cadena de ADN.Para lograr este objetivo, recurrieron a una familia de enzimas llamadas integrasas, que los virus llamados bacteriófagos utilizan para insertarse en los genomas bacterianos.
En trabajos anteriores, los científicos han encontrado difícil desarrollar estas enzimas para la terapia humana porque las plataformas de aterrizaje son muy específicas, y es difícil reprogramar las integrasas para que se dirijan a otros sitios. El equipo del MIT se dio cuenta de que la combinación de estas enzimas con un sistema CRISPR-Cas9 que inserta el lugar de aterrizaje correcto permitiría reprogramar fácilmente el potente sistema de inserción.
La nueva herramieta, PASTE (Programmable Addition via Site-specific Targeting Elements), incluye una enzima Cas9 que corta en un sitio genómico específico, guiada por una cadena de ARN que seunen a ese lugar. Esto les permite dirigire a cualquier sitio del genoma para insertar el sitio de aterrizaje, que contiene 46 pares de bases de ADN. Esta inserción puede realizarse sin itroducir ninguna rotura de doble cadena, añadiendo primero una hebra de ADN a través de una transcriptasa inversa fusionada y luego su hebra complementaria. Una vez incorporado el punto de aterrizaje, la integrasa puede venir e insertar su carga de ADN mucho más grande en el genoma en ese sitio.
En este estudio, los investigadores demostraron que podían utilizar el sistema PASTE para insertar genes en varios tipos de células humanas, como las hepáticas, las células T y los linfoblastos. Probaron el sistema de entrega con 13 genes diferentes de carga útil, icluidos algunos que podrían ser terapéuticos, y fueron capaces de insertarlos en nueve lugares diferentes del genoma.
En estas células, los investigadores pudieron insertar genes con una tasa de éxito que oscilaba entre el 5 y el 60 por ciento. En este método también produjo muy pocos "indels" (inserciones o deleciones) no deseados en los lugares de integración de los genes.
Los investigadores también demostraron que podían insertar genes en hígados "humanizados" de ratones. Los hígados de estos ratones están formados por un 70 por ciento de hepatocitos humanos, y PASTE consiguió integrar nuevos genes en un 2,5 por ciento de estas células.
Las secuencias de ADN que los investigadores insertaron en este estudio tenían una longitud de hasta 36.000 pares de bases, pero creen que también podrían utilizarse secuencias aún más largas. Un gen humano puede tener desde unos cientos hasta más de 2 millones de pares de bases, aunque para fines terapéuticos sólo es necesario utilizar la secuencia codificante de la proteína, lo que reduce drásticamente el tamaño del segmento de ADN que hay que insertar en el genoma.
Los investigadores están estudiando ahora la posiblidad de utilizar esta herramienta como una posible forma de sustituir el gen defectuoso de la fibrosis quística. Esta técnica también podría ser útil para tratar enfermedades de la sangre causadas por genes defectuosos, como la hemofilia y la deficiencia de G6PD, o la enfermedad de Huntington, un transtorno neurológico causado por un gen defectuoso que tiene demasiadas repeticiones.

Comentarios
Publicar un comentario
Gracias por comentar. Te rogamos que seas preciso y educado en tus comentarios.